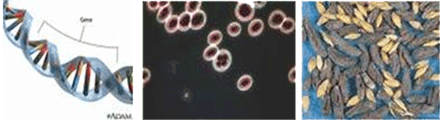

|
|
|
El libre albedrío las culpa de males, pero las
BACTERIAS
SON VIVIFICANTES
Por Boris Cristoff
calle Beyrouth 1272, Montevideo,Uruguay
Tlf. (5982) 6008930, 6002819, 099669387
|
|
|
|
Es consenso entre astrólogos el reconocer que hay un
destino, lo que se opone al libre albedrío defendido por las ciencias oficiales
y universidades. Aunque la puja parece sólo teórica, el libre albedrío es el
origen del aumento de las enfermedades, pandemias y drogadicción, todas ellas
ya casi incontrolables.
 |
|
Las bacterias son los seres
vivos más antiguos. Si es así y convivimos con
ellas interna y externamente, ellas nos
formaron a nosotros
y no al revés.
|
|
|
MEDICINA Y SALUD SE CONTRADICEN
La
Medicina actual está en guerra con los microorganismos como
causantes de todos nuestros males. Su única dirección es administrar drogas
cada vez más potentes para eliminar esos pequeños delincuentes de la salud.
Pero hete aquí la sorpresa: Menos del 1% de todas las bacterias son causantes
de enfermedades y el 99% restante es TOTALMENTE IMPRESCINDIBLE para la vida
humana !!! Entonces ¿de qué estamos hablando? en qué quedamos: las bacterias
son asesinas o son vivificantes?
Esta renguera biológica es un grave defecto para la sanidad
mundial. La salud no está en actuar a la defensiva contra microbios, sino en
una ofensiva sanitaria adoptada desde el nacimiento con hábitos de vida
saludable. La palabra medicina debe bajar sus decibeles a favor de la palabra
SANIDAD, única opción por la vida.
 |
|
Drogas que incitan a otras
drogas e inyecciones. Prótesis.
|
|
 |
|
Vida vegetal como la de
Ariel Sharon. Eutanasia.
|
La
Medicina es una estrecha escalera cuyos escalones son la
droga, la inyección, la prótesis, la vida vegetativa, la eutanasia y la muerte.
Es cómico no darse cuenta que hoy hablar de MEDICINA es hablar de enfermedades
y no de salud. Hablar de salud es hablar de deportes, dietas, naturaleza,
clubes no competitivos, clínicas de vigorización, de excursión, de reposo, etc,
y no de hospitales, droguerías, morgues y cementerios.
 |
| Excursiones,
Balnearioterapia, Descanso, Libertad sexual. |
|
 |
|
Ciudad asfixiante,
Descentralización regional, Ecología.
|
La Salud tiene otra escalera
mucho más grande, porque a grandes males, grandes remedios. Su misión es acabar
con ciudades aglomerantes, descentralización regional, maquinismo no
contaminante, ecología protagonista, dieta de cereales, legumbres y frutas,
actividad física mayoritaria, libertad sexual, fin del dinero y de las
fronteras, del trabajo obligatorio y otros muchos ítems. Aunque parezca mentira,
todo esto que parece inviable ahora, se va a solucionar de golpe a fin de
siglo, como ya ha sucedido cada 2100 años de cada era astrológica.
 |
|
Deportes, Gimnasia, Dietas,
Naturaleza.
|
|
 |
Reuniones, Clubes y
Festejos sociales, Masajes,
Hidroterapia, Tratamientos musculares.
|
LAS BACTERIAS SON
VIVIFICANTES
El 99% de las bacterias tienen funciones insustituibles para
la vida en el planeta. Las bacterias fijan el nitrógeno atmosférico en los
vegetales, que son nuestro alimento fundamental, impulsan el ciclo del carbono
que reincorpora la materia orgánica a los suelos, conviven con nuestro
organismo en nuestro tubo digestivo, sin lo cual no podríamos hacer la
digestión. Dicho de otro modo, la vida Macrobiológica (vegetales y animales
mayores) no podría existir sin la vida Microbiológica (bacterias y virus). Gran
parte de la Industria
no podría existir sin estos micro animales, tal como las fermentaciones
lácteas, las bebidas alcohólicas, los antibióticos, las hormonas, enzimas, los
genes y la producción de proteínas.
TE PRESENTO TU FAMILIA MÁS ÍNTIMA, AUNQUE SEA NADA MÁS QUE
UNA VEZ
 |
Bacteria de hormonas. Bacteria
de la cerveza.
Bacteria de antibiótico.
|
|
 |
Bacteria fija nitrógeno
aéreo.
Bact. del píloro, Bact. reincorpora lo Orgánico
|
|
 |
| Bacteria
del yogur, Bact. De enzimas. Estómago y sus bacterias. |
|
|
|
Bacteria del gen. Bacteria
del pan. Bact. del ácido acético.
|
LA GUERRA A LOS MICROORGANISMOS
La Guerra
médica contra las bacterias y virus comenzó realmente en el siglo pasado, con
el nacimiento de la
Microbiología. Sus investigadores descubrieron esa vida
interna sobre la cual no tenemos arte ni parte, lo que suma un factor más hacia
la existencia del destino. Debo citar que tampoco tenemos arte ni parte al
nacer y al morir, lo cual se conjuga con lo anterior, pero jerárquicamente está
por encima de lo anterior. Ellos prestaron un enorme conocimiento sobre la vida
conjunta que hacemos con los microbios y debiera ser tomado por todos nosotros
en el sentido de colaboración e integración y no de ataque y matanza, de
venenos y aislamientos inconducentes con la vida.
TE PRESENTO LOS CUCOS DE LA HUMANIDAD, AUNQUE SÓLO
SEAN EL 1% DE LA
MICROBIOLOGÍA.
Los virus no crean
enfermedades, depredan a personas y células enfermas, empeorando el mal. No lo
hacen con los sanos.
 |
|
Virus ataca célula enferma.
Foto del virus del Nilo que ataca aves.
|
|
 |
|
Del
SIDA, un virus
inexistente y por eso es un dibujo, nunca fue visto por
nadie.Virus
de la gripe
aviar
|
LA POLÉMICA SOBRE LA GENERACIÓN ESPONTÁNEA
Hace 2.300 años Aristóteles afirmó la generación espontánea.
Fue respetada por dos milenios.
A esto se opuso la ciencia microbiológica, cuyo primer
investigador fue Redi en el siglo XVII. Él colocó en varios frascos trozos de
carne, la mitad esterilizada y sellada y la otra mitad abierta. Días después
los frascos que no habían sido sellados tenían larvas de moscas sobre la carne,
en contraste con los otros frascos que a pesar de haberse podrido, no
presentaban larvas. Creyendo que el aire podría ser el culpable de las larvas,
repitió el experimento colocando una gasa para impedir insectos pero no el
aire, pero los resultados fueron los mismos.
 |
|
Aristóteles
Redi
Nedham
|
|
 |
|
Pasteur
Tyndall |
Quien rompió una lanza a favor de Aristóteles sobre
generación espontánea fue John Nedham, que afirmó la existencia de fuerzas
vitales que animan la materia inerte. Decía que Redi al evitar el aire impedía
la entrada del elemento vital y por ello no aparecían larvas. Es que lo vital y
lo larval conviven.
Pasteur fue el más popular en contra de creación espontánea.
Usó un matraz de cuello en “U” asegurando la entrada del aire pero no la
entrada de microorganismos que quedaban atrapados en un filtro dentro del
cuello. Así aseguró que los alimentos perduraran durante tiempos largos sin
echarse a perder. En años cercanos su valor sobre las vacunas ha sido
cuestionado, por hallarse en sus escritos que forzó resultados que favorecieran
sus investigaciones. El diccionario Larousse informa que un 8% de personas
vacunadas de baja vitalidad mueren por ellas. Es decir que hay que ser muy sano
para recibir vacunas.
John Tyndall estudió física y se interesó por la luz, donde
estudió las partículas suspendidas en el aire. Descubrió que estas partículas
desviaban la luz y que la putrefacción se relacionaba con éstas partículas
suspendidas.
PREGUNTAS DE UN ASTRÓLOGO
Para quienes no hacemos investigaciones como los anteriores
y de manera conceptual hablemos de fenómenos conexos.
UNO.- ¿El nacimiento de nuestro Universo fue espontáneo o fue
inducido por fuerzas externas? Las ciencias afirman que fue espontáneo, que fue
una explosión llamada BIG BANG y que aún está en proceso. Entonces esto
significa que hay una contradicción entre continente y contenido. Si el
Universo manda, todas sus partes lo siguen. Una parte de la Ciencia es respetada por
el espontáneo Big Bang y otra parte es respetada por la No Generación
Espontánea ¿Cómo se digiere esto?
La
espontánea explosión formativa del Universo.
DOS.- ¿Los fenómenos atmosféricos son espontáneos o inducidos?
Cualquiera ha visto documentales con cámara rápida cómo donde hay cielo
claro de pronto comienza a formarse una nube aparecida de la nada. Todo es
espontáneo y no parece inducido. Se dirá que en esos fenómenos atmosféricos hay
factores invisibles que los crean, pero entonces ¿porqué después de tres siglos
de su ciencia, los meteorólogos admiten que no pueden predecir el tiempo por
más de 48 horas?

Nubes
que se forman a ojos vista.
En Astrología vemos a diario causas externas, como las
posiciones de planetas que se sincronizan con inesperados sucesos personales o
colectivos, los cuales no provienen de la Tierra, sino quizás del sistema, de la galaxia o
el universo.
TRES.- Los virus son y no son seres vivientes, tienen una
“vida mineral” y una vida vegetal de manera intermitente. A veces se mueven
como seres y otras veces están inertes como la materia. Además de virus están los
provirus (estado previo a virus), los plásmidos y los viroides. Todos ellos
tienen doble personalidad como Jeckyll y Hyde; mineral y vital.
Por lo tanto, si el virus mineral se saca la careta y
aparece un organismo vivo, entonces hay vida espontánea, aunque no con el
milagro de aparecer de la nada.
Virus en
latín por veneno, toxina.
CUATRO.- Hay unos huevos de tamaño microscópico como si fuera
polvo, los cuales en contacto con el agua salada reviven con toda su
potencialidad. Los huevos de Artemia son organismos en estado latente desde
hace 500 millones de años. Se han vendido en librerías en pequeños sobres con
miles de huevos para hacerlos revivir como experimento doméstico. Es una vida
suspendida, pero se sabe que los organismos vivos no son eternos, sino que
mueren de muerte total, sin atenuantes. Entonces ¿cómo es que estos huevos
eternos como la materia, puede pasar a la categoría de seres vivientes? Debe
haber algo espontáneo no relacionado a nuestro entorno.
Huevos
de artemia. Artemia adulta.
EN SUMA, HAY UNA RESTA
La explicación que he dado muchas veces en mis notas sobre la Tabla Periódica de
la Historia,
es que hay un lapso en la evolución entre materia y vida que son “puentes
evolutivos”. Hay tres de esos puentes que unen los cuatro estados de la
materia: ígneo, sólido, gaseoso y líquido, que en Astrología llamamos Fuego,
Tierra, Aire, Agua. Darwin no soñó más que la evolución de las especies
animales, pero se le escapó la evolución magna de que la animalidad nació de la
vegetalidad, ésta de la materia y ésta última de la gran energía del Big Bang.
Esto nos lleva a afirmar que existe la vida espontánea.
Como la lógica imperante de las ciencias oficiales es el
libre albedrío, entonces consideran que lo espontáneo no puede ser, que algo o
alguien está detrás de ello. Nunca entenderán que el Universo es una Unidad, no
una mafia.

|
|
 |
 |
Pulse aquí para volver a artículos |
 |
 |
Pulse aquí para volver a portada |
|
|
|